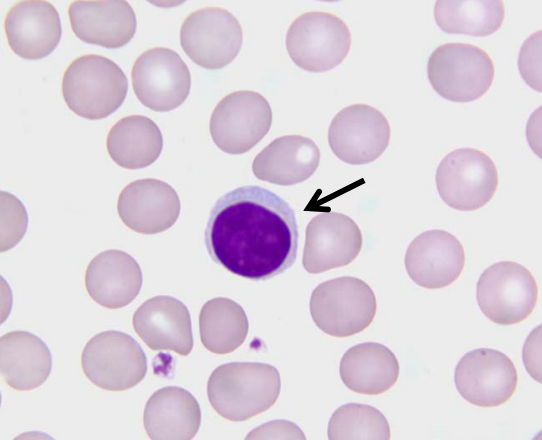
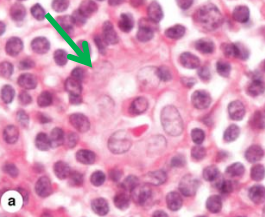
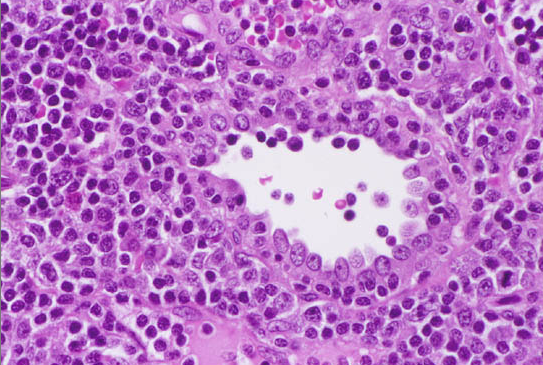
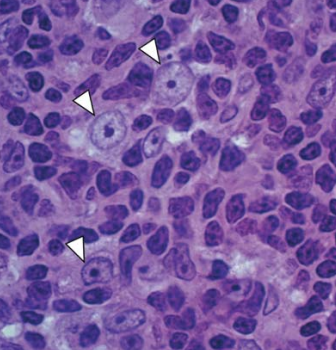

small-medium lymphocyte

reticular fibers and cells

loose and dense lymphoid tissue

Nodular
lymphoid tissue
Primary nodule
(unstimulated)
consist mostly of
B
lymphocytes

secondary lymphatic nodules in a lymph node

gc:
germinal
center in secondayr lymph node
contains
numerous
activated B
lymphocytes
red squares

mantle around germinal centers
red box is ____ in periphery of lymph node

subcapsular
sinus
what is one and two in the thymus?

- cortex and the 2. medulla
6 around a lymph node

capsule
what is 7

subscapular sinus

capsule
_____ tissue in medulla

LOOSE LYMPHOID
MEDULLARY SINUS
___ tissue

DENSE TISSUE
medullary cord
High Endothelial Venules
arrows

lympohocytes
arrow HEADS

high endothelial cells
High endothelial (post-capillary) venule

High endothelial (post-capillary) venule

red arrow
Thymus of an
infant

trabeculae
white arrow - cortex
green arrow - medulla
black arrow

lobule
cortex of fetal thymus
epithelial reticular cells
cortex of thymus

epithelial reticular cells

Hassals corpsulces
present in MEDULLA of thymus













































